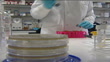
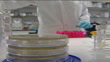

Nottingham: Leslie Ash opens centre to combat "superbug" infections
Nottingham: Leslie Ash opens centre to combat "superbug" infections; Lab technician using pipette to transfer liquid into test tubes (seen beyond petrie dishes in f/g)

PURCHASE A LICENSE
Get personalized pricing by telling us when, where, and how you want to use this asset.
DETAILS
Restrictions:
No use by national or regional TV or radio news in UK and Ireland until 4 days after date of creation. Prior approval required if clip features ITN newsreader or reporter in sound or vision, please contact your local Getty Images representative.No use by regional TV or radio in UK and Ireland until 3 days after date of creation. Prior approval required if clip features ITN newsreader or reporter, please contact your local Getty Images representative.
Credit:
Editorial #:
671303428
Collection:
ITN
Date created:
January 05, 2007
Upload date:
License type:
Rights-ready
Release info:
Not released.ÌýMore information
Clip length:
00:00:16:12
Mastered to:
QuickTime 8-bit Photo-JPEG SD 720x576 25p
Originally shot on:
576 25i
Source:
ITN
Object name:
t05010708_249.mov
- Antibiotic Resistant Videos
- Color Image Videos
- Exchanging Videos
- Film - Moving Image Videos
- Human Interest Videos
- ITV Evening News Videos
- Infectious Disease Videos
- Laboratory Videos
- Leslie Ash Videos
- Liquid Videos
- Nottingham Videos
- Pipette Videos
- Raw Footage Videos
- Real Time Video Videos
- Technician Videos
- Test Tube Videos
- Video with Sound Videos